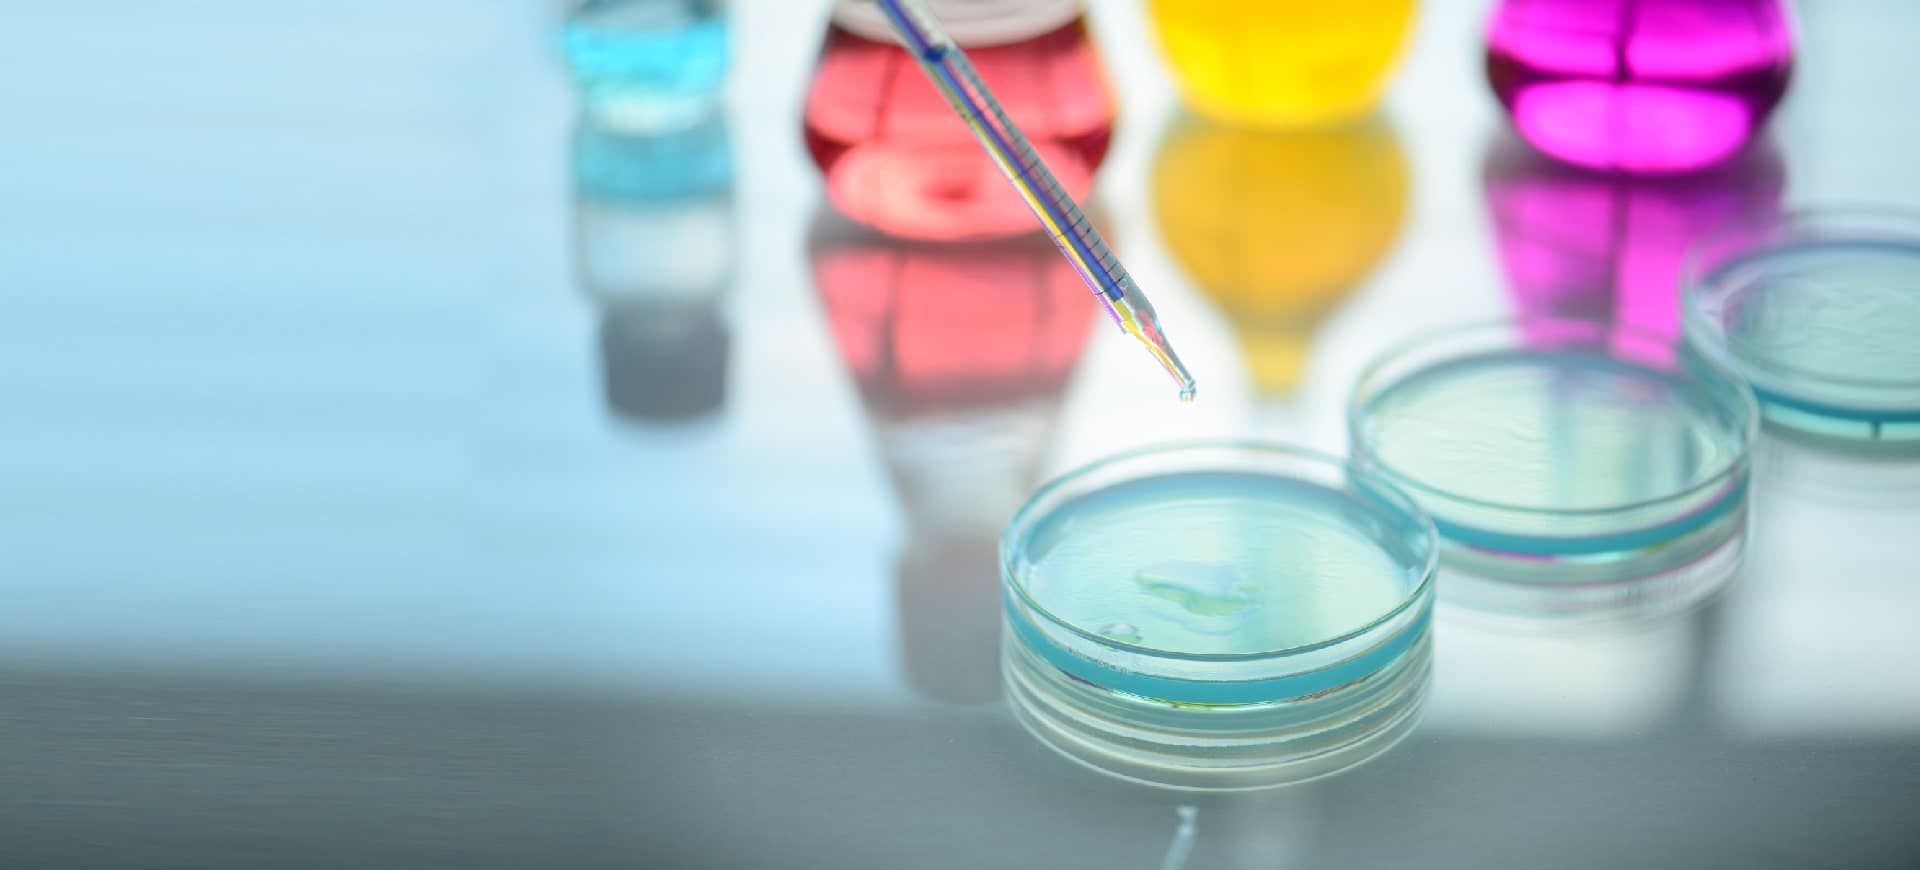
CVR Life Sciences

Intermediate
| Intermediate | Category | CAS Number |
|---|---|---|
| 3-Morpholino-1-(4-nitrophenyl)-5,6-dihydropyridin-2(1H)-one | Apixaban | 503615-03-0 |
| (1-(4-Aminophenyl)-5,6-dihydro-3-(4-morpholinyl)-2(1h)-pyridinone) | Apixaban | 1267610-26-3 |
| Ethyl chloro[(4-methoxyphenyl)hydrazono]acetate | Apixaban | 27143-07-3 |